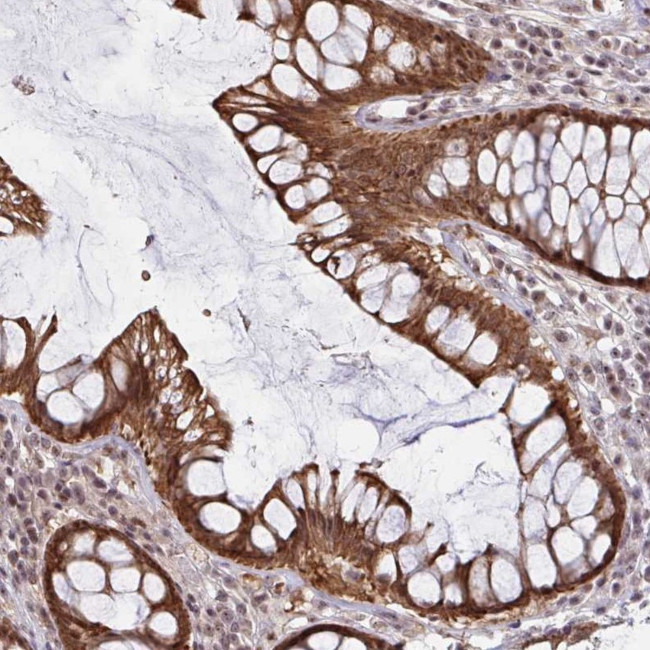
NALP13 Antibody in Immunohistochemistry (Paraffin) (IHC (P))

Search
Invitrogen
NALP13 Polyclonal Antibody
{{$productOrderCtrl.translations['antibody.pdp.commerceCard.promotion.promotions']}}
{{$productOrderCtrl.translations['antibody.pdp.commerceCard.promotion.viewpromo']}}
{{$productOrderCtrl.translations['antibody.pdp.commerceCard.promotion.promocode']}}: {{promo.promoCode}} {{promo.promoTitle}} {{promo.promoDescription}}. {{$productOrderCtrl.translations['antibody.pdp.commerceCard.promotion.learnmore']}}
产品信息
PA5-63859
种属反应
宿主/亚型
分类
类型
抗原
偶联物
形式
浓度
规格
纯化类型
保存液
内含物
保存条件
运输条件
RRID
产品详细信息
Immunogen sequence: LLPYLMALDQ YQLEEFKLCL EPQQLMDFWS APQGHFPRIP WANLRAADPL NLSFLLDEHF PKGQAWKVVL GIFQTMNLTS LCEKVRAEMK ENVQTQELQD PTQED
Highest antigen sequence identity to the following orthologs: Mouse - 25%, Rat - 28%.
靶标信息
NALP proteins are cytoplasmic proteins that form a subfamily within the larger CATERPILLER family and are thought to play a crucial role in cell proliferation and reproduction. Like all other NALP family members, NALP13 has a C-terminal leucine-rich repeat (LRR) region, an N-terminal Pyrin domain (PYD) followed by a NACHT domain, and a NACHT-associated domain. While little is known about the function of NALP13, it has been suggested that it may be implicated in the activation of proinflammatory caspases via inflammasomes.
仅用于科研。不用于诊断过程。未经明确授权不得转售。
篇参考文献 (0)
生物信息学
蛋白别名: NACHT, leucine rich repeat and PYD containing 13; NACHT, LRR and PYD containing protein 13; NACHT, LRR and PYD domains-containing protein 13; Nucleotide-binding oligomerization domain protein 14; nucleotide-binding oligomerization domain, leucine rich repeat and pyrin domain containing 13
基因别名: CLR19.7; NALP13; NLRP13; NOD14; PAN13
UniProt ID: (Human) Q86W25
Entrez Gene ID: (Human) 126204